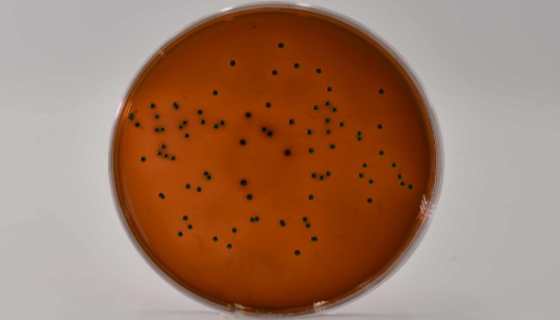
伊红美蓝琼脂培养基（Levine）的使用与实验方法！

毛革盖菌的形态特征与生态习性及经济用途!
毛革盖菌,非褶菌目、韧革菌科、韧革菌属,子实体小至中等大。半...

CCC-HPF-1人胚肺成纤维细胞验收时的注意事项!
人胚肺成纤维细胞CCC-HPF-1取材自引产的15周男性胚胎...

大鼠巨噬细胞的收货处理方法及注意事项有哪些?
大鼠巨噬细胞的培养步骤与收货处理方法及注意事项有哪些?

BRL细胞(大鼠正常肝细胞 )的背景与应用!
BRL细胞是大鼠肝细胞组织来源是肝脏组织,大鼠肝细胞BRL属...
伊红美蓝琼脂培养基(Levine)的使用与实验方法!
伊红美蓝琼脂培养基(Levine)属于弱选择性培养基、用于分...

婴儿双歧杆菌的生理功能与发酵培养及主要应用!
婴儿双歧杆菌是Bifidobacterium属的微生物,原产...

偶发分枝杆菌的特征特点与检测培养及研究进展!
偶发分枝杆菌为条件致病菌,在自然界中广泛存在,进入人体后如抵...

人乳腺上皮细胞的背景与应用及培养操作!
人乳腺上皮细胞分离自乳腺组织;乳腺是复管泡状皮肤腺,主要由腺...

产二素链霉菌的形态特征与主要价值及恢复培养!
产二素链霉菌是Streptomyces属的微生物,原产地为中...